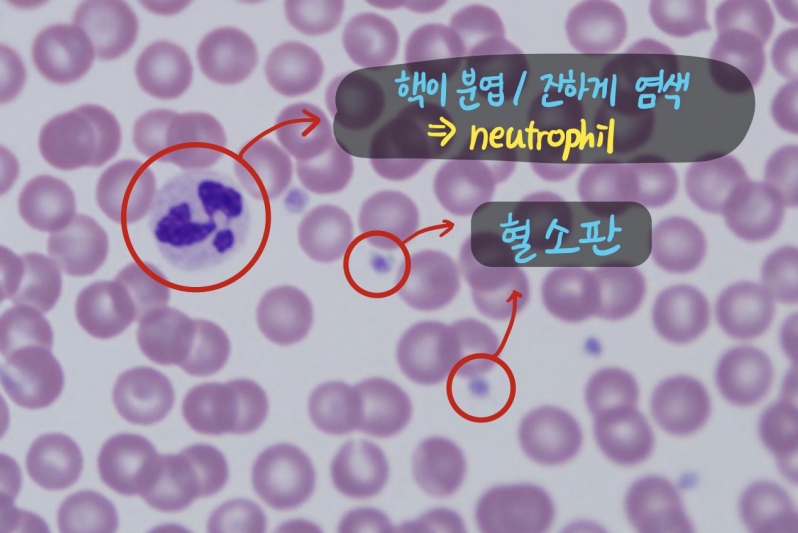
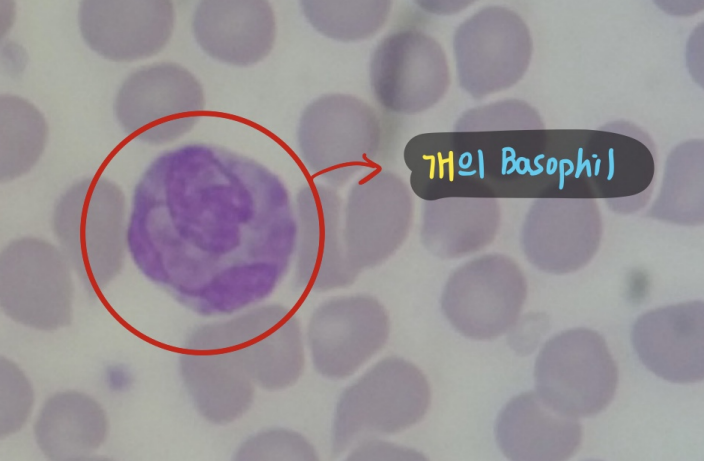
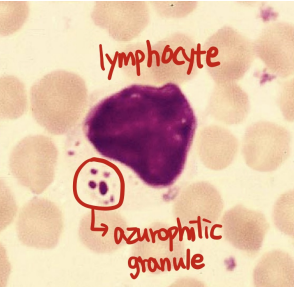

์ ํ๊ตฌ (RBC, erythrocyte)
- ํต์ด ์๋ ์ค๋ชฉํ ์๋ฐ ๋ชจ์ (biconcave disk)
- ๊ฐ์ ์ ํ๊ตฌ : central pallor๊ฐ ๋๋ ทํ๊ฒ ๋ํ๋จ.
- Hemoglobin์ด ์ฃผ๋ณ๋ถ์ ๋ถํฌํ์ฌ ์ค์์ paleํ๊ฒ ๋ณด์ด๋ ๋ถ๋ถ
๋ฐฑํ๊ตฌ (WBC, leukocyte)
Granulocytes
| Neutrophil (ํธ์ค๊ตฌ) | |
|---|---|
![]() ![]() | - ์ ํ๊ตฌ์ 2๋ฐฐ ํฌ๊ธฐ (12-15 ฮผm) - ํต์ด 3~5๊ฐ๋ก ๋ถ์ฝ - heterochromatin โ ์งํ๊ฒ ์ผ์๋จ |
| Eosinophil (ํธ์ฐ๊ตฌ) | |
|---|---|
![]() | - ํต์ด 2๊ฐ๋ก ๋ถ์ฝ๋จ - 10-15 ฮผm - ๊ฐ์์๋ ๊ณผ๋ฆฝ์ด ์ ๊ณ , ๊ณตํฌ(vacuolated) ๊ณผ๋ฆฝ๋ ๋ณด์. |
| Basophil (ํธ์ผ๊ตฌ) | |
|---|---|
![]() | - ํต์ด 2๊ฐ๋ก ๋ถ์ฝ๋จ - 10-15 ฮผm - ์ง์ ๋ณด๋ผ์ - ๊ฐ์์๋ ํต์ด ๋ฆฌ๋ณธ ๋ฌถ์ ๋ชจ์, ๊ณผ๋ฆฝ์ด ์ ๋ณด์. |
Agranulocytes
| Lymphocyte (๋ฆผํ๊ตฌ) | |
|---|---|
![]() ![]() | - ๊ฒํธ๋ฅธ ํต์ด ๊ฑฐ์ ์ฐจ์งํ๊ณ ์์ - azurophilic granule์ด ๋ณด์ด๊ธฐ๋ ํจ |
| Monocyte (๋จํต๊ตฌ) | |
|---|---|
![]() | - 12-18 ฮผm์ ํฐ ์ฌ์ด์ฆ - ๋คํ์ ํต, ์ ๊ฒ ์ผ์๋จ (euchromatin) - ๊ณตํฌ(vacuole) ์กด์ฌ - ์ธํฌ ํ๋ฉด์ microvilli |
Plasma cell
| Plasma cell (ํ์ฅ์ธํฌ) | |
|---|---|
![]() | - ๋ฆผํ๊ตฌ๋ฅผ ๋ฎ์์ผ๋, ๋ฆผํ๊ตฌ๋ณด๋ค ํผ. - ์ฐจ ๋ฐํด ๋ชจ์์ ํต (heterochromatin์ด ํต ์ฃผ๋ณ๋ถ์ ๋ฉ์ด๋ฆฌ์ฒ๋ผ ๋ชจ์ฌ ์์), ํ ์ชฝ์ผ๋ก ์ ๋ ค ์์. - ์ธํฌ์ง์ RER์ด ๋์ basophilic - Russel body ๊ด์ฐฐ : ํญ์ฒด ์ถ์ ๋ ๊ฒ, inclusion body์ฒ๋ผ ๋ณด์. - Golgi complex : ํต ๊ทผ์ฒ์์ ์ผ์๋์ง ์์ ์ฑ๋ก ๊ด์ฐฐ๋จ. |